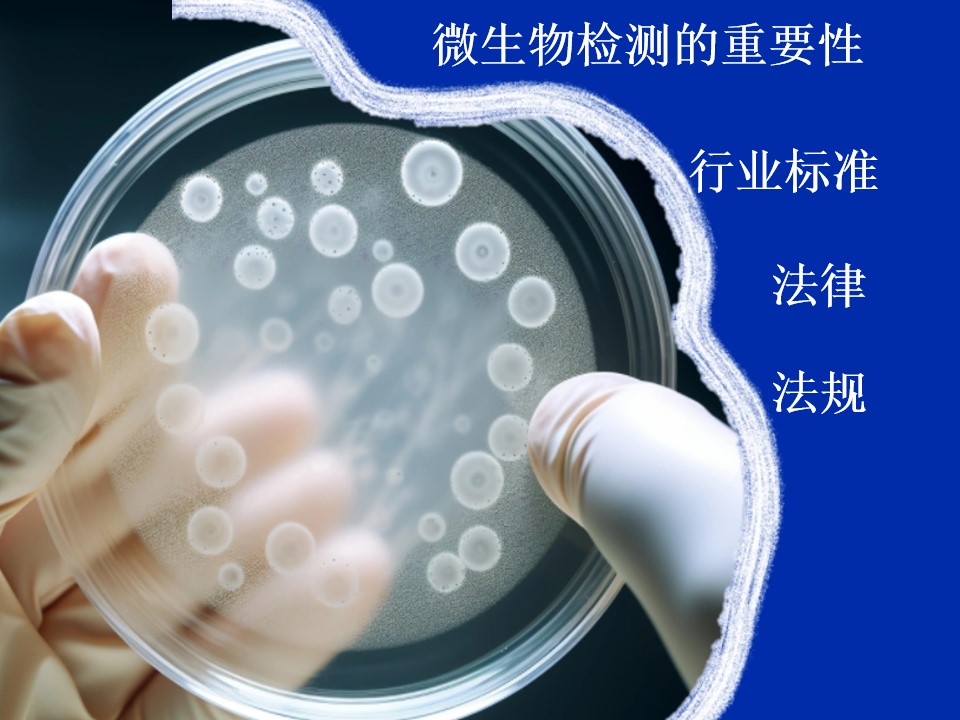

-
 查看详情氮气中的水分对工艺影响很大,不同行业对露点的要求也不同。通过露点法、电解法或气相色谱法检测水分,并严格控制露点,是确保工艺稳定和产品质量的关键。 水分控制的重要性工艺优化:通过控制露点,可以优化充...
查看详情氮气中的水分对工艺影响很大,不同行业对露点的要求也不同。通过露点法、电解法或气相色谱法检测水分,并严格控制露点,是确保工艺稳定和产品质量的关键。 水分控制的重要性工艺优化:通过控制露点,可以优化充... -
 查看详情氮气在包装行业主要通过充氮包装技术实现食品保鲜,其核心作用是防止氧化、抑制微生物生长,并保持食品形状与口感。具体应用包括:主要功能抗氧化:氮气置换包装内氧气,延缓食品氧化变质,尤其适用于薯片、坚果...
查看详情氮气在包装行业主要通过充氮包装技术实现食品保鲜,其核心作用是防止氧化、抑制微生物生长,并保持食品形状与口感。具体应用包括:主要功能抗氧化:氮气置换包装内氧气,延缓食品氧化变质,尤其适用于薯片、坚果... -
 查看详情ISO 8573-1:2010 标准在应用过程中存在几个常见的误解,在压缩空气检测服务中,经常碰到一些对压缩空气的误解,这些误解主要源于对标准定义、现场实现以及检测条件之间差异的认识不足。误解一:实验室洁净度等于现...
查看详情ISO 8573-1:2010 标准在应用过程中存在几个常见的误解,在压缩空气检测服务中,经常碰到一些对压缩空气的误解,这些误解主要源于对标准定义、现场实现以及检测条件之间差异的认识不足。误解一:实验室洁净度等于现... -
 查看详情压缩空气在使用过程中存在许多常见误区,这些误区可能影响设备效率、增加能耗甚至带来安全隐患。以下是几个关键误区的总结:误区一: 忽视系统压力设定认为系统压力设定得越高越好,实际上每提高1 bar压力,能耗会增...
查看详情压缩空气在使用过程中存在许多常见误区,这些误区可能影响设备效率、增加能耗甚至带来安全隐患。以下是几个关键误区的总结:误区一: 忽视系统压力设定认为系统压力设定得越高越好,实际上每提高1 bar压力,能耗会增... -
 查看详情选择检测服务时需考虑以下因素:明确检测哪些项目:根据行业需求选择核心检测项目,通常包括:露点(湿度):确保压缩空气干燥度,避免管路腐蚀或微生物滋生。油分:含油量需≤0.1mg/m³,防止设备腐蚀或产品...
查看详情选择检测服务时需考虑以下因素:明确检测哪些项目:根据行业需求选择核心检测项目,通常包括:露点(湿度):确保压缩空气干燥度,避免管路腐蚀或微生物滋生。油分:含油量需≤0.1mg/m³,防止设备腐蚀或产品... -
 查看详情压缩空气质量受多种因素影响,主要可分为设备、环境、操作及维护四类,具体如下:一、设备相关因素空压机类型与状态无油空压机可减少油污染,但若吸入环境中的油颗粒(如烟草行业),仍会导致碳氢化合物残留。...
查看详情压缩空气质量受多种因素影响,主要可分为设备、环境、操作及维护四类,具体如下:一、设备相关因素空压机类型与状态无油空压机可减少油污染,但若吸入环境中的油颗粒(如烟草行业),仍会导致碳氢化合物残留。... -
 查看详情压缩空气品质检测仪器的选型需综合考虑行业标准、污染物类型及检测精度要求,以下为关键选型标准及方法:污染物等级划分依据《GB/T 13277.1-2023》和《ISO 8573-1》,压缩空气需检测颗粒物、水分、油分三类...
查看详情压缩空气品质检测仪器的选型需综合考虑行业标准、污染物类型及检测精度要求,以下为关键选型标准及方法:污染物等级划分依据《GB/T 13277.1-2023》和《ISO 8573-1》,压缩空气需检测颗粒物、水分、油分三类... -
查看详情压缩空气微生物含量检测是保障工业安全与产品质量的关键环节,其重要性主要体现在以下几个方面:行业标准与法规要求医药与食品行业GMP规范明确要求与药品/食品直接接触的压缩空气必须符合微生物限度标准1无...
查看详情压缩空气微生物含量检测是保障工业安全与产品质量的关键环节,其重要性主要体现在以下几个方面:行业标准与法规要求医药与食品行业GMP规范明确要求与药品/食品直接接触的压缩空气必须符合微生物限度标准1无...
压缩空气检测专家-大湾检测技术(上海)有限公司 欢迎您!


 专业压缩气体 | CDA | N2
专业压缩气体 | CDA | N2 全国定制热线:
全国定制热线:

